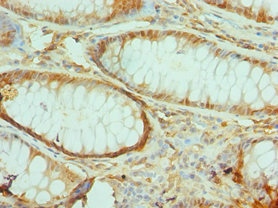

TIRAP Antibody
-
中文名稱:TIRAP兔多克隆抗體
-
貨號:CSB-PA023570ESR1HU
-
規(guī)格:¥440
-
圖片:
-
Western blot
All lanes: Toll/interleukin-1 receptor domain-containing adapter protein antibody at 2μg/ml
Lane 1: K562 whole cell lysate
Lane 2: Mouse kidney tissue
Secondary
Goat polyclonal to rabbit IgG at 1/10000 dilution
Predicted band size: 24, 26, 28 kDa
Observed band size: 24 kDa -
Immunohistochemistry of paraffin-embedded human colon cancer using CSB-PA023570ESR1HU at dilution of 1:100
-
Immunohistochemistry of paraffin-embedded human liver tissue using CSB-PA023570ESR1HU at dilution of 1:100
-
-
其他:
產(chǎn)品詳情
-
產(chǎn)品名稱:Rabbit anti-Homo sapiens (Human) TIRAP Polyclonal antibody
-
Uniprot No.:
-
基因名:
-
別名:TIRAP antibody; MAL antibody; Toll/interleukin-1 receptor domain-containing adapter protein antibody; TIR domain-containing adapter protein antibody; Adaptor protein Wyatt antibody; MyD88 adapter-like protein antibody; MyD88-2 antibody
-
宿主:Rabbit
-
反應(yīng)種屬:Human, Mouse
-
免疫原:Recombinant Human Toll/interleukin-1 receptor domain-containing adapter protein (1-221AA)
-
免疫原種屬:Homo sapiens (Human)
-
標(biāo)記方式:Non-conjugated
-
克隆類型:Polyclonal
-
抗體亞型:IgG
-
純化方式:Antigen Affinity Purified
-
濃度:It differs from different batches. Please contact us to confirm it.
-
保存緩沖液:PBS with 0.02% sodium azide, 50% glycerol, pH7.3.
-
產(chǎn)品提供形式:Liquid
-
應(yīng)用范圍:ELISA, WB, IHC
-
推薦稀釋比:
Application Recommended Dilution WB 1:200-1:1000 IHC 1:20-1:200 -
Protocols:
-
儲存條件:Upon receipt, store at -20°C or -80°C. Avoid repeated freeze.
-
貨期:Basically, we can dispatch the products out in 1-3 working days after receiving your orders. Delivery time maybe differs from different purchasing way or location, please kindly consult your local distributors for specific delivery time.
-
用途:For Research Use Only. Not for use in diagnostic or therapeutic procedures.
相關(guān)產(chǎn)品
靶點詳情
-
功能:Adapter involved in TLR2 and TLR4 signaling pathways in the innate immune response. Acts via IRAK2 and TRAF-6, leading to the activation of NF-kappa-B, MAPK1, MAPK3 and JNK, and resulting in cytokine secretion and the inflammatory response. Positively regulates the production of TNF-alpha and interleukin-6.
-
基因功能參考文獻(xiàn):
- TIRAP is phosphorylated at Thr28 within its phosphoinositide (PI)-binding motif (PBM), which leads to its ubiquitination and degradation. The authors demonstrate that phosphorylation distorts the helical structure of TIRAP PBM, reducing PI interactions and cell membrane targeting. PMID: 28225045
- MAL is not disulfide-bonded and requires glutathionylation of C91 for signaling. PMID: 28739909
- The Mal-Toll/interleukin-1 receptor (TIR) domains AB loop is capable of mediating direct binding to the TIR domains of TLR4 and MyD88 simultaneously. PMID: 22485159
- MAL is multifunctional and integral for the molecular control of bacterial infections as well as inflammatory diseases. [Review] PMID: 23983209
- Data indicate that TcpB (Q8YF5, BtpA/Btp1) interacts with MAL, MyD88, and TLR4 but interferes only with the MAL-TLR4 interaction. PMID: 24265315
- Docking and physicochemical studies indicated that BTK was involved in close contact with Tyr86 and Tyr106 of MAL, whereas PKCdelta may phosphorylate Tyr106 only. PMID: 24840642
- Results show that MAL protein binds to and regulates MYD88. PMID: 26876098
- Here the authors show that MAL TIR domains spontaneously and reversibly form filaments in vitro. They also form cofilaments with TLR4 TIR domains and induce formation of MyD88 assemblies. PMID: 28759049
- The major allele A of rs2511521 located in DRD2 and the minor allele T of rs625413 located in TIRAP are significantly associated with increased risk of food addiction in overweight/obese subjects with low/zero food addiction symptoms. PMID: 28115213
- Combined targeting of UBAP1 and toll-like receptor adaptors TIRAP and MyD88 by Pseudomonas aeruginosa PumA impedes both cytokine and toll-like receptor signalling, highlighting a novel strategy for innate immune evasion. PMID: 28483816
- Epistatic interaction between MyD88 and TIRAP against Helicobacter pylori. PMID: 27296467
- Presence of at least one copy of the TIRAP (2054C > T) variant may be associated with severity of bronchopulmonary dysplasia among preterm neonates. PMID: 27457283
- Chances of malaria caused by Plasmodium falciparum were low in CC genotype carriers in comparison to other genotypes PMID: 26614847
- TIRAP polymorphisms are associated with progression and survival of patients with symptomatic myeloma. PMID: 26564000
- This present meta-analysis suggests TIRAP C539T polymorphism is significantly correlated with reduced risk of TB infection, with stronger effect in European. PMID: 25003251
- Evaluated the possible association between TIRAP rs1893352 and rs8177374 (S180L) gene polymorphisms and pulmonary tuberculosis in a sample of Iranian population. PMID: 25066393
- CCL2rs2530797A/A and TIRAPrs8177376A/A were associated to an increase susceptibility to Chagas disease cardiomyopathy. PMID: 24330528
- TIRAP rs81777374 is associated with resistance to pulmonary tuberculosis. PMID: 24067789
- Data indicate that TcpB (NP_540591) may mimic the function of TIRAP through their similar TIR domain structures. PMID: 24275656
- PSP has an immunoregulatory effect through regulation of the TLR4-TIRAP/MAL-MyD88 signaling pathway. PMID: 23802631
- the results of our study suggest that there is a defect of TIRAP and MyD88 proteins in B-CLL lymphocytes. PMID: 23419703
- TIRAP S180L polymorphism is not increased in Behcet's disease patients in Italian or Turkish populations. PMID: 24064014
- In our study, a TLR pathway adapter variant (TIRAP (rs8177374)) protected against preterm birht<32 weeks, supporting our hypothesis that genetic variation in the innate immune signaling pathway contributes to altered risk of PTB. PMID: 23047423
- MyD88 exerts antiapoptotic functions in colon cancer cells via the Ras/Erk, but not the NF-kappaB, pathway. MyD88 inhibition leads to defective ERCC1-dependent DNA repair and to accumulation of DNA damage, resulting in cancer cell death via p53. PMID: 23766530
- Identification of binding sites for myeloid differentiation primary response gene 88 (MyD88) and Toll-like receptor 4 in MyD88 adapter-like (Mal). PMID: 23460645
- PIP5Kalpha promotes TLR4-associated microglial inflammation by mediating PIP(2)-dependent recruitment of TIRAP to the plasma membrane PMID: 23297396
- Compared to white women, African American women with clinically suspected pelvic inflammatory disease were more likely to carry variants in the TLR1, TLR2, and TIRAP genes. PMID: 23255565
- induction of both IL-6 and IL-8 is associated with elevated TIRAP and reduced TRAM mRNA expression PMID: 22970235
- Data suggest a protection effect of the Mal/TIRAP S180L SNP against serious infections in HIV-1 infected individuals with low CD4 cell counts. PMID: 22683004
- Data indicate that MyD88 works together with the IL-1/IL-18 receptors, can interact with two distinct sorting adaptors, TRAM and Mal, in a conserved manner. PMID: 22685567
- Poxviral protein A46 inhibits TLR4 signaling and interacts with Toll-IL-1 receptor (TIR) domain-containing proteins of the receptor complex. PMID: 22593572
- TIRAP S180L polymorphism is unlikely to substantially contribute to tuberculosis susceptibility (Meta-analysis) PMID: 21419702
- Blocking of the function of TIRAP and MyD88 largely abrogated intracellular signaling from ligand-activated RAGE PMID: 21829704
- TIRAP G286A (D96N) polymorphism is associated with susceptibility to tuberculosis. PMID: 21218381
- TIRAP 180Leu was significantly associated with Behcet's disease in UK, but not Middle Eastern, patients. PMID: 21705416
- a molecular and structural basis for the role of MAL in TLR signaling and disease protection. PMID: 21873236
- RA synovium showed abundant expression of TLR. RA synovitis tissue seems to be responsive to TLR ligands. PMID: 21324962
- Comparison of the tirap S180L genotypes between patients with mild malaria and those healthy individuals showed that the frequency of heterozygosity was significantly higher in infected than non-infected individuals. PMID: 21457584
- Data demonstrate a key role for Mal in mediating TLR2 and TLR4 activation of CREB and induction of CREB-responsive genes including Il-10. PMID: 21398611
- Genetic variations in MyD88 adaptor-like are associated with atopic dermatitis PMID: 21399862
- TIRAP gene might be associated with susceptibility to sepsis-associated acute lung injury in the Han Chinese population. PMID: 21118491
- Patients simultaneously carrying polymorphisms in TIRAP/Mal and TLR4 and patients homozygous for the TIRAP/Mal SNP had a significantly higher risk of severe infections after surgery PMID: 20525286
- The recessive homozygous genotype for a single-nucleotide polymorphisms in the TIRAP (also known as MAL) gene (rs1893352) was strongly associated with nonmeningitis cases of haemophilus influenzae serotype b vaccine failure. PMID: 20804371
- An Asp96Asn single nucleotide polymorphism prevents Mal from recruiting its signaling partner MyD88 to the plasma membrane and fails to induce NF-kappa B signaling in human tumor line Huh-7 hepatocytes. PMID: 20164415
- Data show that AIP1 is a novel GTPase-activating protein for Arf6, a small GTPase regulating cellular PIP(2) production and formation of the TLR4-TIRAP-MyD88 complex. PMID: 19948740
- A TIR domain variant of MyD88 adapter-like (Mal)/TIRAP results in loss of MyD88 binding and reduced TLR2/TLR4 signaling. PMID: 19509286
- Polymorphisms in TIRAP do not appear to be involved in childhood tuberculosis susceptibility in South Africa, but may play a role in determining occurrence of tubercular meningitis PMID: 19693265
- MyD88 and Mal/TIRAP are essential for LPS-induced I kappa B alpha phosphorylation, NF-kappa B activation, and interleukin 6 (IL-6) or IL-8 production in fibroblasts and endothelial cells in a pathway that also requires IKK2. PMID: 14630816
- involvement of a previously uncharacterized, evolutionarily conserved TIR domain protein in innate immunity that is functionally distinct from other known TIR domain signaling adapters PMID: 15123841
- activation of Rac1 leads to HIV-LTR trans-activation, mediated through TIRAP. Rac1 and TIRAP are important in TLR4 activation of HIV replication PMID: 15187145
顯示更多
收起更多
-
亞細(xì)胞定位:Cytoplasm. Cell membrane. Membrane. Note=Colocalizes with DAB2IP at the plasma membrane.
-
組織特異性:Highly expressed in liver, kidney, spleen, skeletal muscle and heart. Also detected in peripheral blood leukocytes, lung, placenta, small intestine, thymus, colon and brain.
-
數(shù)據(jù)庫鏈接:
Most popular with customers
-
-
YWHAB Recombinant Monoclonal Antibody
Applications: ELISA, WB, IHC, IF, FC
Species Reactivity: Human, Mouse, Rat
-
Phospho-YAP1 (S127) Recombinant Monoclonal Antibody
Applications: ELISA, WB, IHC
Species Reactivity: Human
-
-
-
-
-